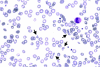

Coagulation abnormalities in critically ill patients
- PMID: 16879728
- PMCID: PMC1750988
- DOI: 10.1186/cc4975
Coagulation abnormalities in critically ill patients
Abstract
Many critically ill patients develop hemostatic abnormalities, ranging from isolated thrombocytopenia or prolonged global clotting tests to complex defects, such as disseminated intravascular coagulation. There are many causes for a deranged coagulation in critically ill patients and each of these underlying disorders may require specific therapeutic or supportive management. In recent years, new insights into the pathogenesis and clinical management of many coagulation defects in critically ill patients have been accumulated and this knowledge is helpful in determining the optimal diagnostic and therapeutic strategy.
Figures

References
Publication types
MeSH terms
LinkOut - more resources
Full Text Sources
Other Literature Sources
Medical

